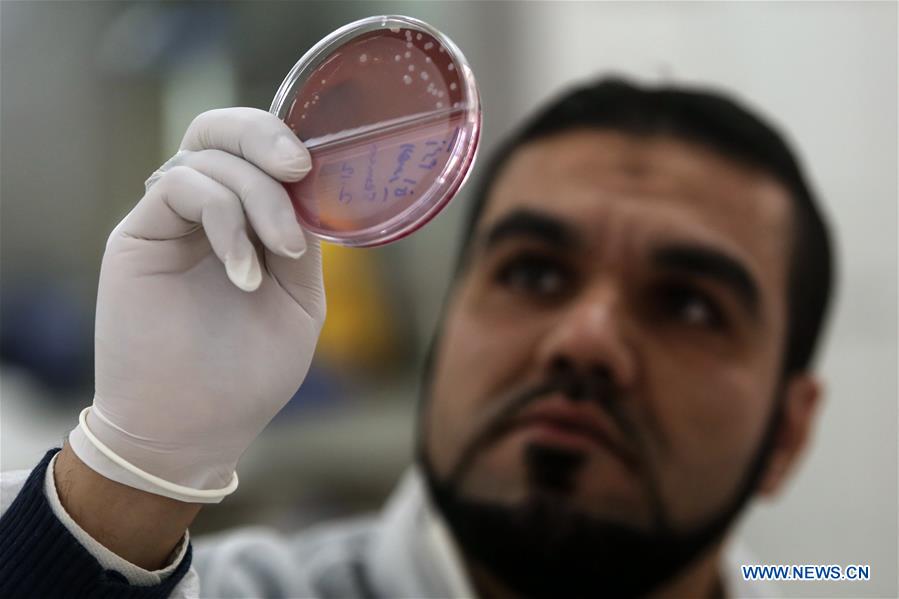
MIDEAST-GAZA-ANTIBIOTIC-NANOTECHNOLOGY

A Palestinian scientist works in a laboratory in Gaza City, on Dec. 5, 2018. A team of young Palestinian scientists from the Gaza Strip is looking to develop antibiotics and fungus by nanotechnology. The team, which is composed of three young people, recently won the first place in the competition of innovation health sector at the level of universities in the Gaza Strip. (Xinhua/Stringer)














